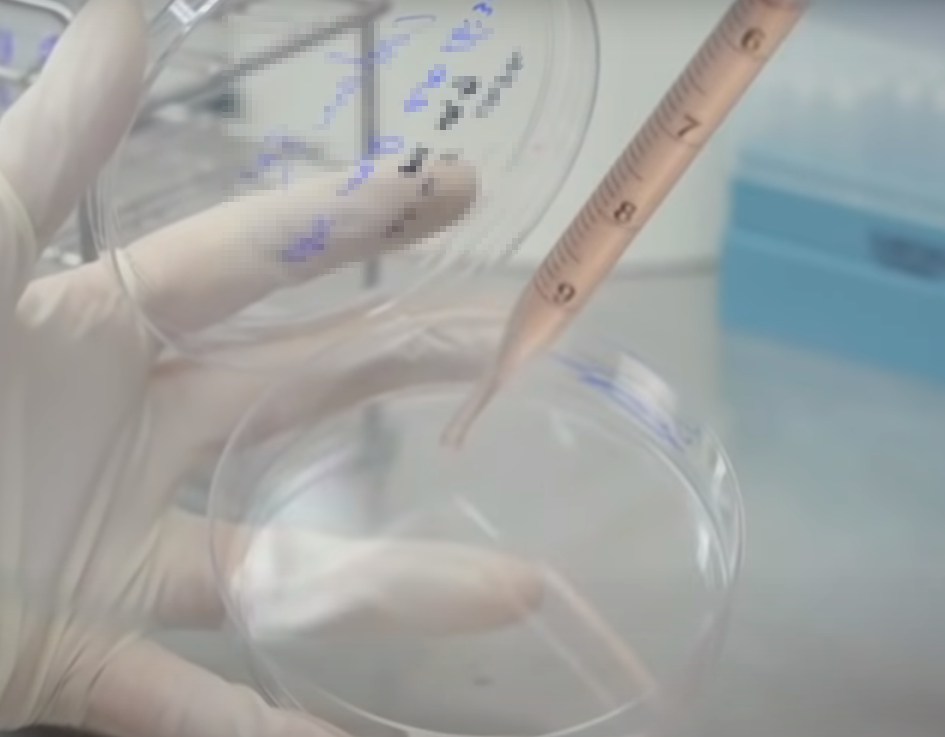

불가리스 남양유업 전현직 직원 불구속 기소
불가리스 남양유업의 전 직원들이 자사 제품인 불가리스에 대해 코로나19 억제 효과가 있다고 주장한 것에 대해 검찰이 기소했다는 소식입니다. 서울중앙지검은 이광범 남양유업 전 대표이사, 박종수 전 항VIRUS 면역연구소장, 그리고 현직 본부장급 임원 2명 등 총 4명의 남양유업 전현직 직원을 불구속 기소하였습니다. 이들의 혐의는 식품표시광고법 위반 혐의입니다.



이들은 2021년 4월 개최된 학술 심포지엄에서 자사 제품인 불가리스가 코로나19를 예방과 치료를 할 수 있다고 광고한 혐의를 받았습니다. 이 발표가 있은 후 당시 마트에서는 불가리스가 동나는 등 엄청난 인기를 얻었습니다. 하지만 질병관리청에서는 심포지엄에서 발표한 연구결과가 사람을 대상으로 연구한 것이 아니므로 효과를 얻기 어렵다고 반박하였습니다.

원숭이 실험으로 바이러스 줄었다고 발표
당시 남양유업은 자사 제품 불가리스를 먹으면 코로바 바이러스를 억제할 수 있다고 하였습니다. 바이러스가 77.8%나 감소하였다고 구체적인 숫자까지 제시하며 광고하였습니다. 이 발표로 남양유업 주가는 8% 넘게 상승하였고, 남양유업 제품도 사재기에 들어가 품귀 현상이 발생하기도 하였습니다.
원숭이 폐 세포에 코로나 바이러스를 넣은 후 불가리스 제품을 섞었더니 바이러스가 77.8% 감소하였다는 것인데 일각에서는 소독제가 바이러스를 얼마나 줄였는지 하는 실험과 비슷하다는 지적입니다.



사람을 대상으로 한 실험도 아니었고, 또 사람을 대상으로 했다 하더라도 2천명 이상 실험해서 데이타를 얻어야 하는데 너무 원시적인 실험이라고 지적한 바 있습니다.
현재 이 사안은 재판 절차에 들어갔으며, 재판 결과에 따라 적절한 처벌이 이뤄질 것으로 예상됩니다. 이는 소비자의 건강과 안전을 보호하기 위해 식품 광고에 관한 법규를 준수하는 것의 중요성을 강조하는 사례로 평가될 수 있습니다. 더 자세한 사안은 재판이 진행되는 과정에서 밝혀질 것입니다.
'이모저모' 카테고리의 다른 글
| 부동산 거래 급감으로 공인중개사 인기도 시들 (0) | 2023.12.30 |
|---|---|
| 정우성도 천만 관객 배우, 서울의 봄 천만 관객 돌파 (0) | 2023.12.30 |
| 현대자동차 아토즈 개조모델 쌍트로 인기 (0) | 2023.12.13 |
| 러시아 출산율 높이기 위해 세금 도입 (0) | 2023.12.05 |
| 사기 전과 등 전과가 있으면 개명이 가능할까요? (0) | 2023.10.26 |